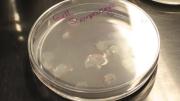
Científicos españoles desarrollan córneas artificiales a partir de escamas de pescado

Mundo
11 de marzo de 2026 Página 1
Mundo
Haití: Ataques con drones al crimen organizado dejan más de 1.200 muertos en un año
Las fuerzas de seguridad de Haití y contratistas privados que trabajan con ellas han llevado a cabo extensos ataques letales con drones que podrían constituir violaciones del derecho internacional, según señaló Human Rights Watch (HRW). Los ataques, que en algunos casos... + más
EE.UU. excluye a Colombia del Escudo de las Américas por “no cooperar lo suficiente”

Estados Unidos creó la Shield of the Americas, un bloque militar que reúne a doce gobiernos de la región, con el fin de coordinar acciones contas contra el narcotráfico y el crimen organizado. Resumen Síntesis generada con OpenAI Estados Unidos explicó que no invitó a... + más
En marcha trabajos para mejorar infraestructura de la Escuela Brasil

POR CARLOS ARIAS MORA TALCA. GEn marcha se encuentran las faenas de refacción de la zona norte de la Escuela Brasil, trabajos que implican una inversión de casi 300 millones de pesos. Al respecto, el jefe subrogante del Departamento de Administración de Educación Municipal... + más
Violenta riña en la cárcel dejó un reo muerto y otro con heridas de gravedad

POR LEONARDO PAREDES ZAPATA FOTO CARLOS ALARCÓN DUARTE TALCA. Un recluso muerto y otro con heridas de gravedad dejó una violenta riña en el antigua Cárcel de Talca ocurrida pasado el mediodía de ayer y que generó gran conmoción en la comunidad. La agresión se desató... + más
Tipos de Apuestas Deportivas: Guía Completa 2024 | El Martutino
Partido de fútbol amateur en Buin termina con violenta riña entre barristas: no hay detenidos | BioBioChile
Femicidios

Señor director: En este 8M, es importante volver a reflexionar sobre la violencia contra la mujer, uno de los mayores “dolores” en la sociedad. En Chile, las cifras siguen mostrando una estabilidad preocupante del femicidio. Lejos de observar una reducción, el indicador... + más
Radiografía a los femicidios en Chile: quiénes son las víctimas y cómo ocurrieron los crímenes en 2024 | La Tercera
Gobierno desmiente a Kast por dichos sobre femicidios: “Es falso” | ADN
“Uno de los más moderados de su familia”: Quién es Flávio Bolsonaro, senador brasileño que estará en el cambio de mando

El senador confirmó su presencia en nuestro país, invitado por el equipo del Presidente electo José Antonio Kast, lo que habría derivado en la ausencia del mandatario brasileño, Lula da Silva. Señal T13 En Vivo El cambio de mando generó una polémica que traspasó... + más
Por favor, sueño con poder vivir sin tanto dolor: niño con piel de mariposa hace desgarradora súplica ante el parlamento europeo

Si mi piel fuera la de ustedes, por un solo día, sé que haríais todo para cambiar las cosas, suplicó el pequeño. En Chile, en los últimos 12 años, los pacientes con piel de mariposa han crecido en un 47%. Señal T13 En Vivo Un desgarrador relato entregó un niño de tan... + más
EE.UU. alerta a civiles iraníes que se alejen de puertos y advierte que podrían convertirse en blancos
Las Fuerzas Armadas de Estados Unidos emitieron este miércoles una alerta a la población iraní para que evite las instalaciones portuarias civiles desde donde las fuerzas navales de Irán realizan ataques en el estrecho de Ormuz. En dicha alerta, se advierte que no podrán... + más
ONU acusa al régimen de Ortega de desviar fondos públicos para financiar la represión en Nicaragua

VER RESUMEN Resumen generado con una herramienta de Inteligencia Artificial desarrollada por BioBioChile y revisado por el autor de este artículo. La ONU acusa a Nicaragua de desviar fondos públicos para reprimir la oposición tanto dentro como fuera del país, mediante una... + más
Flávio Bolsonaro critica ausencia de Lula en cambio de mando de Kast: “Aún no puede coexistir con quienes piensan diferente a él”
El senador y precandidato presidencial brasileño, Flávio Bolsonaro, criticó duramente la ausencia del mandatario Luiz Inácio Lula da Silva en la ceremonia de investidura del nuevo presidente chileno, José Antonio Kast. En una visita oficial a Chile, donde, según él, fue... + más
“Es un perseguido político”: Flávio Bolsonaro defiende a su padre en su llegada al cambio de mando presidencial
El senador brasileño Flávio Bolsonaro, principal candidato de la derecha a las elecciones de octubre, llegó ayer a nuestro país para participar del cambio de mando presidencial. Consultado en las afueras del Congreso Nacional sobre la candidatura de Michelle Bachelet a la... + más
¿Qué se sabe del acuerdo económico que Trump planea para Cuba sin cambiar al régimen, según USA Today?
Desde el inicio de este año, miembros cercanos a la Administración Trump han filtrado a la prensa información sobre acercamientos entre Washington y funcionarios en La Habana con el fin de identificar posibles piezas dentro del aparato castrista que estén dispuestas a... + más
Científicos españoles desarrollan córneas artificiales a partir de escamas de pescado
Desde la Universidad de Granada, investigadores en España han desarrollado córneas artificiales a partir de escamas de pescado.... + más
Javier Milei se autoproclama desde EEUU como el presidente más sionista del mundo

VER RESUMEN Resumen generado con una herramienta de Inteligencia Artificial desarrollada por BioBioChile y revisado por el autor de este artículo. El presidente de Argentina, Javier Milei, se autodeclaró el mandatario más sionista del mundo al defender su apoyo a Estados... + más
Jefe de seguridad iraní advierte a Trump que cuide su espalda porque podría ser eliminado

VER RESUMEN Resumen generado con una herramienta de Inteligencia Artificial desarrollada por BioBioChile y revisado por el autor de este artículo. El secretario del Consejo Supremo de Seguridad Nacional de Irán, Ali Lariyani, advirtió al presidente de EEUU, Donald Trump, que... + más
Corea del Norte lanza misiles entre ensayos del Sur y EE.UU.

El líder norcoreano, Kim Jong-un, supervisó un lanzamiento de prueba de misiles de crucero, según informó este miércoles (11.03.2026) la agencia estatal KCNA, entre los ejercicios militares conjuntos en curso de Corea del Sur y Estados Unidos, unas maniobras que Pyongyang... + más
Juan Guaidó llegará a Chile para el cambio de mando y se suma a María Corina Machado

VER RESUMEN Resumen generado con una herramienta de Inteligencia Artificial desarrollada por BioBioChile y revisado por el autor de este artículo. El ex presidente encargado de Venezuela, Juan Guaidó, llegará a Chile para asistir a la ceremonia de cambio de mando... + más
Policía iraní amenaza con tratar “como al enemigo” a quien salga a protestar contra el régimen
La policía de Irán advirtió este martes de que si alguien sale a protestar en el país “a petición del enemigo”, será tratado “como el enemigo”.El cuerpo policial defendió que las fuerzas de seguridad se emplearán en la “protección de su revolución... + más
“No consigue convivir con quien piensa diferente”: Hijo de Bolsonaro arremete contra Lula por no asistir a investidura de Kast

El hijo del expresidente Jair Bolsonaro, quien sí participará en la ceremonia, dijo en una entrevista que la decisión de cancelar el viaje a Chile refleja odio por parte del actual mandatario. (EFE) – El senador brasileño Flávio Bolsonaro, principal candidato de la... + más
El consulado ruso en Irán fue dañado durante un ataque a un edificio del gobierno local, dice Rusia

Según la portavoz del Ministerio de Relaciones Exteriores de Rusia, Maria Zakharova la onda expansiva del ataque empujó hacia atrás a varios empleados y rompió ventanas del edificio del consulado y de apartamentos residenciales cercanos. (CNN) – El Consulado General de... + más
El Pentágono afirma que Irán “está solo y perdiendo” la guerra y anuncia el día “más intenso” de bombardeos
El secretario de Defensa estadounidense, Pete Hegseth, ha afirmado este martes que “hoy será, de nuevo, el día más intenso de ataques dentro de Irán”, unas palabras que llegan en el undécimo día de una ofensiva lanzada el pasado 28 de febrero por Estados Unidos e... + más
Trump insiste en posible toma de control amistosa de Cuba en medio de crisis energética

Este lunes, el presidente de Estados Unidos, Donald Trump insistió en la posibilidad de que su país lleve a cabo una toma de control amistosa de Cuba, en medio de la grave crisis energética y económica que enfrenta la isla. Durante una conferencia de prensa en Miami, el... + más
EE.UU.: Broma fallida terminó con profesor muerto y escolar imputado por homicidio

Un profesor de secundaria murió atropellado por un estudiante que huía después de gastarle una broma en su residencia en el estado de Georgia (EE.UU.). Jason Hughes, de 40 años, salió de su vivienda con la intención de sorprender a cinco estudiantes que estaban lanzando... + más
Bullrich confirma extradición de Galvarino Apablaza a Chile: “Argentina no puede ser tierra que refugie asesinos”
La senadora argentina Patricia Bullrich confirmó que Argentina avanzará en la extradición a Chile de Galvarino Apablaza, requerido por la justicia chilena como presunto autor intelectual del asesinato del senador Jaime Guzmán. En declaraciones difundidas por la prensa... + más
Notibol. Desde 2006. Central de Noticias.
Notibol es un agregador informático de noticias y no es responsable del contenido de los enlaces a los sitios externos que generan las noticias.
Acerca de Notibol | Contacto | Política de Privacidad | Descargo de Responsabilidad











